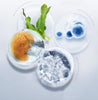
Herbal Lightening Acne Cream Skin Care

Categories
Custom Services
-
Free Delivery
From $59.89
-
Support 24/7
Online 24 hours
-
Free return
365 a day
-
payment method
Secure payment
Herbal Lightening Acne Cream Skin Care
Regular price $96.85
Product information:
Name: acne cream
Product Efficacy: Contains anti-acne essence to help solve skin acne problems and reduce frequent acne. Cool texture, delicate and soft to leave skin feeling clean and clear
Main ingredients: niacinamide, gum arabic, salicylic acid, sodium hyaluronate
Hydrolyzed Royal Jelly Protein, Quaternary Ammonium Salt-73, Fullerene
Precautions:
1. Before using the product, please try it behind the ear or inside the arm without discomfort or allergy before continuing to use it
2. This product contains salicylic acid, which should not be used by children under the age of three. Salicylic acid is actually used in this product as a skin conditioner only
Packing list:
Herbal acne cream*1





Your order of 100$ or more gets free standard delivery.
- Standard delivered 4-5 Business Days
- Express delivered 2-4 Business Days
Orders are processed and delivered Monday-Friday (excluding public holidays)
eMarket members enjoy free returns.